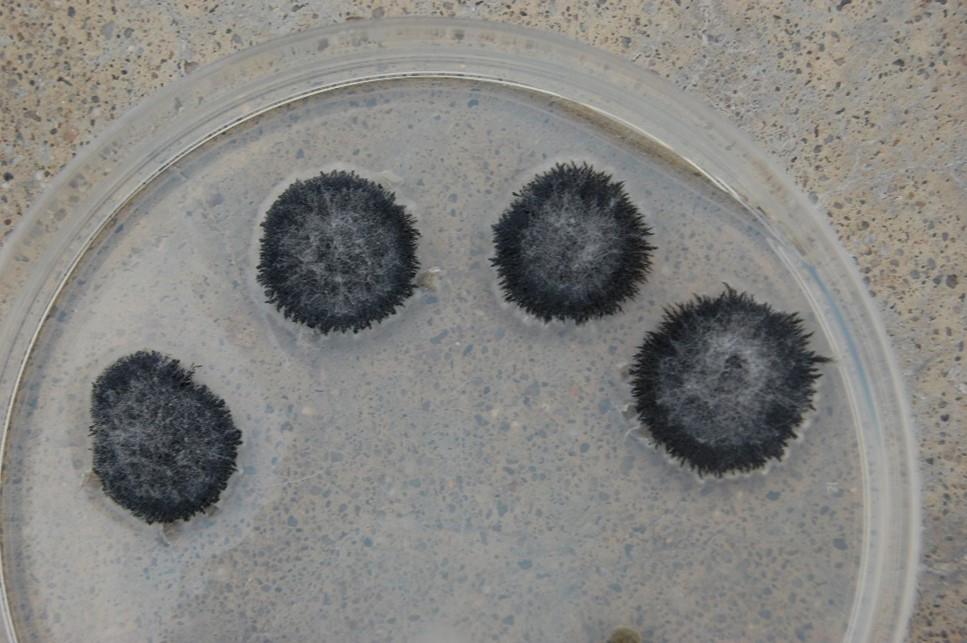

Symptoms and Signs
Symptoms of Verticillium wilt are typically observed at or near flowering growth stages and can be present on a single plant or on a group of plants in a field. The initial symptoms develop on the lower leaves of the plants and consist of small, yellow (chlorotic) areas between leaf veins (Fig. 1). These chlorotic areas become necrotic and brown-colored and are still surrounded by yellow chlorotic tissue, which gives the leaves a mottled appearance (Fig. 2). Symptoms, which first appear on lower leaves, gradually move up the stem from the base to the top of infected plants. Ultimately, the leaves on affected plants wilt and die (Gulya et al. 1997; Harveson and Markell 2016) (Fig. 3). At times, the vascular tissue inside the stem develops a reddish-brown discoloration (Fig. 4). In severely affected plants, the pith and exterior of the stem may be covered with thousands of gray- to black-colored microsclerotia and appear black (Fig. 5). These microsclerotia can survive in the soil without a host for at least 14 years (Wilhelm 1955).
Foliar symptoms caused by
V. dahliae may resemble the leaf symptoms of Phomopsis stem canker, which is caused by
Diaporthe species (Mathew et al. 2018). In the case of Phomopsis stem canker, the tissues between the affected leaf veins may turn chlorotic and eventually necrotic, leading to premature leaf death. Brown-colored lesions can be seen on the exterior of the stems during the flowering growth stages, and over time, the stems become weak and hollow. However, in the case of Verticillium wilt, brown-colored lesions may not be present on the stem exterior, and the interior of infected stems appears black when cut in cross-section (Sadras et al. 2000) (Fig. 6).

Figure 1. Early symptoms with interveinal lesions
| 
Figure 2. Necrosis appearing on chlorotic lesions giving a mottling symptoms
| 
Figure 3. Affected, lower leaves begin to die
|

Figure 4. Reddish-brown discolored vascular elements in lower stalk of an infected plant (top) compared with a healthy one (bottom)
| 
Figure 5. External (top) and internal (below) symptoms on stalks of infected plants showing the microsclerotia of V. dahliae
| 
Figure 6. Cross section of an Verticillium wilt-infected sunflower plant
|
Disease Cycle and Pathogen Identification
V. dahliae can be spread within and between fields as conidia and microsclerotia, through surface irrigation water, infested soil, and/or infested seeds. In addition, considering the mycelium of the fungus can colonize the pericarp and testa of seeds (Sackston 1980), the transmission of
V. dahliae may be facilitated between countries via seed shipments (Zhang et al. 2018). The disease cycle is illustrated in an article by Berlanger and Powelson (2000).
Disease development is favored by moist soil conditions and temperatures of 21 to 27°C (70 to 81°F). Infection on sunflower plants occurs when microsclerotia germinate and penetrate roots (Sadras et al. 2000; Wilhelm 1955). Germination of microsclerotia is stimulated by exudation from roots to the soil. The fungus penetrates the root and colonizes the cortex by producing hyphae. The fungal hyphae continue to invade the xylem vessels, and numerous conidia are formed at the hyphal apex. These conidia are transported through the xylem to the aerial parts of the plant. As a result, the infected sunflower exhibits wilting, stunting, and foliar chlorosis and necrosis.
The slow-growing fungus can often be identified by conidiospores (spore-bearing structures) that are arranged in whirls surrounding a central axis (Fig. 7). This type of spore arrangement is referred to as "verticillate," which gives the fungus its name. In pure cultures, the fungal growth is black (Fig. 8) due to the masses of tiny microsclerotia that are formed in chains from hyphal cells (Fig. 9) (Harveson 2009).

Figure 7. “Verticillate” conidiospores diagnostic for
Verticillium
|
Figure 8. Black mycelial growth characteristic of V. dahliae
|  Figure 9. Microsclerotia forming in chains of V. dahlia in culture. Figure 9. Microsclerotia forming in chains of V. dahlia in culture.
|
Pathogen Biology
To date, the sexual stage of
V. dahliae has not been identified. It is considered an asexual fungus, and the conidia produced by
V. dahliae in the xylem vessels help the fungus adapt to the ecological niche (Luo et al. 2016; Tian and Kong 2022).
Strains of
V. dahliae have been classified into vegetative compatibility groups (VCG) based on the ability of the vegetative fungal hyphae from different individual isolates to fuse and form stable heterokaryons. VCGs are typically determined using nitrate non-utilizing (nit) auxotrophic mutants, which are prepared on a medium with nitrate as the nitrogen source. Isolates that form stable heterokaryons with
nit mutants and produce wild-type growth on the medium are vegetatively compatible and placed in the same VCG (Martín-Sanz et al. 2018). In addition to complementation tests with
nit mutants, VCG characterization of
V. dahliae isolates has been performed using molecular diagnostic markers (Carder et al. 1994; Collado-Romero et al. 2009; García-Carneros et al. 2014; Mercado-Blanco et al. 2001, 2002, 2003).
To date, isolates of sunflower have been characterized as VCG 1, VCG 2A, VCG 2B, VCG 4A, VCG 4B, or VCG 6 (Alananbeh et al. 2011; El-Bebany et al. 2013; García-Carneros et al. 2014). In a greenhouse experiment by Mathew (2014), it was observed that isolates of
V. dahliae belonging to VCGs 4B and 2B caused significantly greater disease severity (70–100% chlorosis and necrosis) on the susceptible confection inbred 'HA 288' at 49-days postinoculation when compared with isolates characterized as VCGs 1, 2A, 4A, and 6. However, only a few representative isolates were evaluated in the Mathew (2014) study. Nonetheless,
V. dahliae isolates belonging to the same VCG may be genetically distinct populations that have a similar host range, pathogenicity, and physiological and ecological traits (Collado-Romero et al. 2009; Martín-Sanz et al. 2018).
In a few crops, such as cotton (Gossypium sp.),
V. dahliae isolates may be characterized as defoliating or nondefoliating pathotypes, based on the ability of the isolates to remove healthy leaves due to disease. (Bejarano-Alcázar et al. 1996). On sunflower, using sequence characterized amplified region (SCAR) markers, Martín-Sanz et al. (2018) showed that
V. dahliae isolates obtained from Eastern Europe (Bulgaria, Romania, and Turkey), were defoliating pathotypes, while those from Western Europe (France, Italy, Spain, and Ukraine) and Argentina were nondefoliating pathotypes. However, the Martín-Sanz et al. (2018) study did not evaluate differences in pathogenicity among
V. dahliae isolates identified as defoliating and nondefoliating pathotypes.
In addition to pathotypes, races of
V. dahliae have been described based on their ability to overcome single resistance genes. In the United States, the first race (NA-1) was identified when it could overcome a single major resistance gene (V1) in the inbred line HA89 (Gulya 2007a, b; Gulya et al. 1997). Following the identification of NA-1, new races were identified based on phenotypic characterization, which included four races (VArg1, VArg2, VArg3, and VArg4) in Argentina identified using the inbred lines ADV29 and ADV53 (Clemente et al. 2017) and one race ('Verticillium race 2 West Europe' [V2-WE]) that could overcome the V1 gene in HA89 in Spain (García-Ruiz et al. 2014). In Europe, three races were identified, including 'Verticillium race 2 East Europe' (V2-EE), which causes disease on INRA2603 and not on HA89; V2-WE, which is pathogenic on HA89 and not INRA2603; and V1, which is controlled by both HA89 and INRA2603 (Martín-Sanz et al. 2018). Since INRA2603 and HA89 are public inbred lines that are resistant and/or susceptible to
V. dahliae, Martín-Sanz et al. (2018) proposed that these genotypes can be used as differentials to identify pathogenic races, in addition to HA458 (which is universally susceptible).
Disease Management
Verticillium wilt is a monocyclic disease, and therefore, management strategies aim to reduce the amount of initial inoculum and prevent the disease.
Crop rotation: Rotating sunflower with corn (Zea mays L.), wheat (Triticum sp.), or other nonhosts for at least three years can help reduce pathogen inoculum in fields.
Tillage: Wheeler et al. (2020) examined the effect of tillage practices (conventional and reduced tillage) on Verticillium wilt, microsclerotia density, and cotton yield. The use of reduced tillage reduced the density of microsclerotia and improved yield. However, such studies have not been performed in sunflower fields to determine the effectiveness of tillage practices against
V. dahliae.

Figure 10. Infected common cocklebur plant caused by Verticillium wilt
|
Weed management: Weeds in sunflower fields, such as
Abutilon theophrasti (velvetleaf),
Amaranthus spp. (amaranth, pigweed),
Ambrosia spp. (ragweed),
Chenopodium album (lambsquarter),
Cirsium arvense (Canada thistle),
Datura spp. (jimsonweed),
Malva spp. (mallow),
Polygonum persicari (smartweed),
Senecio vulgaris (groundsel),
Solanum nigrum (black nightshade),
Sonchus oleraceus (sowthistle), and
Xanthium spp. (cocklebur) (Fig. 10), are potential reservoirs for species of
Verticillium and must be managed.
Chemical control: No fungicides are currently labeled for use on sunflower against species of
Verticillium, and research on chemical control is limited. As an example, a study by Addrah et al. (2019) showed that soaking sunflower seeds in flusilazole fungicides (Fungicide Resistance Action Committee 3, Demethylation Inhibitors—Triazole) for 12 h before planting may help control contamination of
V. dahliae in seeds.
Genetic resistance: Genetic resistance is the most effective strategy to control Verticillium wilt in sunflower, as demonstrated over the last five decades. In the 1950s, sources of resistance to
V. dahliae were identified in Canada (Putt 1958), and the inheritance of resistance (designated as V1) was determined to be qualitative (Putt 1964). The V1 genes were identified in USDA inbred lines (e.g., HA89) in the 1970s (Fick and Zimmer 1974); these lines are used to develop resistant hybrids in public breeding programs. However, races of
V. dahliae that were not controlled by V1 genes in HA89 (NA-Vd2) emerged in the United States (Gulya 2007a, b) and Argentina (Bertero de Romano and Vazquez 1984; Bruniard et al. 1984). Radi and Gulya (2007) identified new sources of resistance to NA-Vd2 in the USDA sunflower germplasm, such as PI507901 and Interstate 4575 NS. In addition, Gulya et al. (1997) identified the inbred lines HA300 and HA371 to be resistant to NA-Vd2. Bruniard et al. (1984) developed the lines V144, V99, V134, and V196 with resistance to the Argentine race NA-Vd2 (Škorić 2016). The mechanism of resistance to NA-Vd2 may be recessive or additive in a few inbred lines, and breeders in Argentina considered improving resistance to
V. dahliae by pyramiding quantitative trait loci (QTLs) associated with resistance to races VArg1 and VArg2 (Galella et al. 2012). In the study by Galella et al. (2012), near-isogenic lines (L1: resistance to VArg1; L2: resistance to VArg2) with the resistance QTLs for races VArg1 and VArg2; F3 and F4 families (obtained by crossing L1 and L2); and a susceptible variety (L51) were evaluated for their resistance to the two races in a growth chamber and under natural inoculum. It was observed that F4 families were resistant to VArg1 and VArg2, and no significant differences in oil content or yield were observed between F4 lines and the parents (Galella et al. 2012).
Researchers have screened wild sunflower species to identify sources of resistance to
V. dahliae. As an example, Hoes et al. (1973) screened 46 collections of wild
Helianthus (6 collections of
H. annuus from the Canadian provinces of Manitoba and Saskatchewan and 34 collections of
H. annuus and 6 collections of
H. petiolaris from 12 U.S. states). It was observed that
H. petiolaris was more resistant than
H. annuus. In addition, the F1, F2, and F3 families developed by crossing resistant wild species with a susceptible inbred were also resistant, and their frequency distributions suggest the inheritance of resistance to be dominant or recessive. Pustovoit and Krokhin (1978) screened interspecific hybrids (cultivated
H. annuus ×
H. tuberosus) to
V. dahliae and identified the inheritance of resistance to be recessive or complementary dominant (two to three genes), which can hinder developing resistant genotypes. Škorić (1984) determined
H. occidentalis,
H. hirsutus, and
H. tuberosus to be partially resistant to
V. dahliae.
Significance
Verticillium wilt has been a major disease of sunflower in Argentina, Bulgaria, France, Italy, Romania, Spain, Turkey, Ukraine, and the United States (Debaeke et al. 2017; Galella et al. 2012; Gulya et al. 1997; Harveson and Markell 2016; Radi and Gulya 2007). However, disease prevalence in the United States has decreased between 2014 and 2023 (F. Mathew,
personal observation). Regardless, transmission of seed by
V. dahliae has been documented (Klosterman et al. 2009), which can facilitate the spread of the fungus to current and new sunflower production areas worldwide. In addition,
V. dahliae has a broad host range of more than 350 plant species (Berlanger and Powelson 2000; Ryley et al. 2021) that may be rotated with sunflowers or present in commercial sunflower fields as weed species. The current management options for sunflower farmers are limited to crop rotation with nonhosts, weed management, and the use of commercial hybrids with resistance or tolerance to
V. dahliae. Considering the genetic and pathogenic diversity of
V. dahliae, it was proposed that the races of the fungus be determined using the three differentials and public inbred lines (HA458 [susceptible], HA89, and INRA2603) to develop commercial hybrids with effective resistance to the fungus (Martin-Sanz et al. 2018). At this time, management options are limited to crop rotation with nonhosts, weed management, and the use of resistant hybrids (if available).
References
Addrah, M. E., Zhang, Y., Zhang, J., Liu, L., Zhou, H., Chen, W., and Zhao, J. 2019. Fungicide treatments to control seed-borne fungi of sunflower seeds. Pathogens 9(1):29. doi: 10.3390/pathogens9010029
Alananbeh, K., Gudmestad, N., Gulya, T., and Markell, S. 2011. Determination of presumptive vegetative compatibility groups of Verticillium dahliae occurring on sunflower using molecular markers. Abstr. Phytopathology 101(6S):S4.
Bejarano-Alcázar, J., Blanco-López, M. A., Melero-Vara, J. M., and Jiménez-Díaz, R. M. 1996. Etiology, importance and distribution of Verticillium wilt of cotton in southern Spain. Plant Dis. 80:1233-1238. doi: 10.1094/PD-80-1233
Berlanger, I., and Powelson, M. L. 2000. Verticillium wilt. Plant Health Instructor. Online doi: 10.1094/PHI-I-2000-0801-01
Bertero de Romano, A., and Vazquez, A. N. 1984. Verticillium dahliae Kleb. Estimacion de perdidas de rendimiento pare distintas intensidades de ataque. In: Proc. 11th Int. Sunflower Conf. Mar del Plata, Argentina. Intl. Sunflower Conf. Toowoomba, Aust. 2:379-384.
Bruniard, J. M., Luduena, P. M., and Ivanovich, A. 1984. Selection of sunflower lines with resistance to Verticillium dahliae Kleb./IDIA 413/416. Estac. Exp. Reg. Agropec. INTA, Pergamino, Argentina. Pages 96-98.
Carder, J. H., Morton, A., Tabrett, A. M., and Barbara, D. J. 1994. Detection and differentiation by PCR of subspecific groups within two Verticillium species causing vascular wilts in herbaceous hosts. Pages 91-97 in: Modern Assays for Plant Pathogenic Fungi. A. Schots, F. M. Dewey, and R. Oliver, eds. CAB International, Oxford.
Clemente, G. E., Bazzalo, M. E., and Escande, A. R. 2017. New variants of Verticillium dahliae causing sunflower leaf mottle and wilt in Argentina. J. Plant Pathol. 99:445-451. doi: 10.4454/jpp.v99i2.3875
Collado-Romero, M., Berbegal, M., Jiménez-Díaz, R. M., Armengol, J., and Mercado-Blanco, J. 2009. A PCR-based 'molecular toolbox' for in planta differential detection of Verticillium dahliae vegetative compatibility groups infecting artichoke. Plant Pathol. 58:515-526.
Creus, C., Bazzalo, M. E., Grondona, M., Andrade, F., and León, A. J. 2007. Disease expression and ecophysiological yield components in sunflower isohybrids with and without Verticillium dahliae resistance. Crop Sci. 47:703-710.
Debaeke, P., Bedoussac, L., Bonnet, C., Bret-Mestries, E., Seassau, C., Gavaland, A., Raffaillac, R., Tribouillois, H., Véricel, G., and Justes, E. 2017. Sunflower crop: Environmental-friendly and agroecological. Oléagineux Corps Lipides 24(3). Online doi: D304 10.1051/ocl/2017020
El-Bebany, A. F., Alkher, H., Lorne, R. A., and Daayf, F. 2013. Vegetative compatibility of Verticillium dahliae isolates from potato and sunflower using nitrate non-utilizing (nit) mutants and PCR-based approaches. Can. J. Plant Pathol. 35:1-9.
Fick, G. N., and Zimmer, D. E. 1974. Monogenic resistance to Verticillium wilt in sunflowers. Crop Sci. 14:603-604. doi: 10.2135/cropsci1974.0011183X001400040036x
Galella, M. T., Bazzalo, M. E., Morata, M., Cimmino, C., Kaspar, M., Grondona, M., Reid, R., Zambelli, A., and León, A. 2012. Pyramiding QTLs for Verticillium dahliae resistance. Pages 219-224 in: Vol. 1. Proc. 18th Int. Sunflower Conf. Mar del Plata, Argentina. ISA, Paris.
García-Carneros, A. B., García-Ruiz, R., and Molinero-Ruiz, L. 2014. Genetic and molecular approach to Verticillium dahliae infecting sunflower. Helia 37:205-214. doi: 10.1515/helia-2014-0014
García-Ruiz, R., García-Carneros, A. B., and Molinero-Ruiz, L. 2014. A new race of Verticillium dahliae causing leaf mottle of sunflower in Europe. Plant Dis. 98:1435. doi: 10.1094/PDIS-04-14-0360-PDN
Gulya, T. 2007a. New strain of Verticillium dahliae in North America. Helia 30:115-120. doi: 10.2298/HEL0747115G
Gulya, T., Harveson, R., Mathew, F., Block, C., Thompson, S., Kandel, H., Berglund, D., Sandbakken, J., Kleingartner, L., and Markell, S. 2019. Comprehensive disease survey of U.S. sunflower: Disease trends, research priorities and unanticipated impacts. Plant Dis. 103:601-618.
Gulya, T., Rashid, K. Y., and Masirevic, S. M. 1997. Sunflower diseases. Pages 263-379 in: Sunflower Technology and Production. Agron. Monogr. 35. A. A. Schneiter, ed. American Society of Agronomy, Madison, WI.
Gulya, T. J. 2007b. Distribution of Plasmopara halstedii races from sunflower around the world. In: Advances in Downy Mildew Research. A. Lebeda and P. T. N. Spencer-Phillips, eds. Proc. 2nd Int. Downy Mildew Symp. 3:121-134.
Harveson, R. M. 2009. Verticillium wilt of sunflowers in Nebraska. NebGuide G1963. University of Nebraska, Lincoln, NE.https://extensionpublications.unl.edu/assets/pdf/g1963.pdf
Harveson, R. M., and Markell, S. G. 2016. Verticillium wilt. Pages 59-61 in: Compendium of Sunflower Diseases and Pests. R. M. Harveson, S. G. Markell, C. C. Block, and T. J. Gulya, eds. American Phytopathological Society, St. Paul, MN.https://doi.org/10.1094/9780890545096
Hoes, J. A., Putt, E. D., and Enns, H. 1973. Resistance to Verticillium wilt in collections of wild Helianthus in North America. Phytopathology 63:1517-1520.
Klosterman, S. J., Atallah, Z. K., Vallad, G. E., and Subbarao, K. V. 2009. Diversity, pathogenicity, and management of Verticillium species. Annu. Rev. Phytopathol. 47:39-62.
Luo, X., Mao, H., Wei, Y., Cai, J., Xie, C., Sui, A., Yang, X., and Dong, J. 2016. The fungal specific transcription factor Vdpf influences conidia production, melanized microsclerotia formation and pathogenicity in Verticillium dahliae. Mol. Plant Pathol. 17:1364-1381.
Martín-Sanz, A., Rueda, S., García-Carneros, A. B., González-Fernández, S., Miranda-Fuentes, P., Castuera-Santacruz, S., and Molinero-Ruiz, L. 2018. Genetics, host range, and molecular and pathogenic characterization of Verticillium dahliae from sunflower reveal two differentiated groups in Europe. Front. Plant Sci. 9:288. doi: 10.3389/fpls.2018.00288
Mathew, F., Harveson, R., Gulya, T., Thompson, S., Block, C., and Markell, S. 2018. Phomopsis stem canker of sunflower. Plant Health Instructor. Online doi: 10.1094/PHI-I-2018-1103-01
Mathew, F. M. 2014. Molecular characterization and pathogenicity of sunflower stem pathogens. Ph.D. dissertation, North Dakota State University Repository, Fargo, ND.https://hdl.handle.net/10365/27484
Mercado-Blanco, J., Rodríguez-Jurado, D., Parrilla-Araujo, S., and Jiménez-Díaz, R. M. 2003. Simultaneous detection of the defoliating and nondefoliating Verticillium dahliae pathotypes in infected olive plants by duplex, nested polymerase chain reaction. Plant Dis. 87:1487-1494.
Mercado-Blanco, J., Rodríguez-Jurado, D., Pérez-Artés, E., and Jiménez-Díaz, R. M. 2001. Detection of the nondefoliating pathotype of Verticillium dahliae in infected olive plants by nested PCR. Plant Pathol. 50:609-619.
Mercado-Blanco, J., Rodríguez-Jurado, D., Pérez-Artés, E., and Jiménez-Díaz, R. M. 2002. Detection of the defoliating pathotype of Verticillium dahliae in infected olive plants by nested-PCR. Eur. J. Plant Pathol. 108:1-13.
Pereyra, V., Quiroz, F., Agüero, M., and Escande, A. 1999. Relación del rendimiento de girasol con la intensidad de síntomas provocados por V. dahliae. In: Proceedings of the X Jornadas Fitosanitarias Argentinas 35.
Pustovoit, G. V., and Krokhin, E. J. 1978. The inheritance of resistance to major pathogens in interspecific sunflower hybrids. Pages 40-44 in: VNIIMK Review: Pests and Diseases of Oil Crops, Krasnodar. (In Russian).
Putt, E. D. 1958. Note on resistance of sunflowers to leaf mottle disease. Can. J. Plant Sci. 38:274-276. doi: 10.4141/cjps58-044
Putt, E. D. 1964. Breeding behavior of resistance to leaf mottle disease or Verticillium in sunflowers. Crop Sci. 4:177-179. doi: 10.2135/cropsci1964.0011183X000400020016x
Quiroz, F., Erreguerena, I., Clemente, G., and Escande, A. 2012. Impacto de la marchitez por Verticillium dahliae sobre el rendimiento de girasol. In: XIV Jornadas Fitosanitarias Argentinas. UNSL—FICES 165.
Radi, S., and Gulya, T. 2007. Sources of resistance to a new strain of Verticillium dahliae on sunflowers in North America–2006. Pages 10-11 in: Proceedings of the 29th Sunflower Research Workshop Bismarck, ND.
Ryley, M., Gulya, T., Mathew, F., Thompson, S., Block, C., Markell, S., and Harveson, R. 2021. Sunflower wilt diseases: Charcoal rot, Phialophora yellows, and Verticillium wilt. Plant Health Prog. 22:75-85.
Sackston, W. E. 1980. Some factors influencing infection of sunflower seed by Verticillium dahliae. Can. J. Plant Pathol. 2:209-212.
Sadras, V. O., Quiroz, F., Echarte, L., Escande, A., and Pereyra, V. R. 2000. Effect of Verticillium dahliae on photosynthesis, leaf expansion and senescence of field-grown sunflower. Ann. Bot. 86:1007-1015.
Škorić, D. 1984. Genetic resources in the Helianthus genus. Pages 37-73 in: Proc. Int. Symp. Sci. Biotechnol. Integral Sunflower Utilization, Bary, Italy.
Škorić, D. 2016. Sunflower breeding for resistance to abiotic and biotic stresses. In: Abiotic and Biotic Stress in Plants—Recent Advances and Future Perspectives. InTech. Online doi: 10.5772/62159
Tian, J., and Kong, Z. 2022. Live-cell imaging elaborating epidermal invasion and vascular proliferation/colonization strategy of Verticillium dahliae in host plants. Mol. Plant Pathol. 23:895-900.
Wang, D., Su, Z., Ning, D., Zhao, Y., Meng, H., Dong, B., Zhao, J., and Zhou, H. 2021. Different appearance period of Verticillium wilt symptoms affects sunflower growth and production. J. Plant Pathol. 103:513-517. doi:https://doi.org/10.1007/s42161-021-00772-x
Wheeler, T. A., Bordovsky, J. P., Keeling, J. W., Keeling, W., and McCallister, D. 2020. The effects of tillage system and irrigation on Verticillium wilt and cotton yield. Crop Prot. 137:105305. Online doi: doi.org/10.1016/j.cropro.2020.105305
Wilhelm, S. 1955. Longevity of Verticillium wilt fungus in the laboratory and field. Phytopathology 45:180-181.
Zhang, Y., Zhang, J., Gao, J., Zhang, G., Yu, Y., Zhou, H., Chen, W., and Zhao, J. 2018. The colonization process of sunflower by a green fluorescent protein-tagged isolate of Verticillium dahliae and its seed transmission. Plant Dis. 102:1772-1778.
